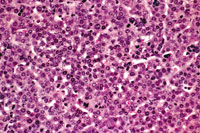
AL-TAg Mouse Liver

Much of the work carried out by DTT is in support of the National Toxicology Program (NTP), an interagency partnership of the Food and Drug Administration, National Institute for Occupational Safety and Health, and NIEHS.
The Digitized Atlas of Mouse Liver Lesions
Liver from a 2-week old wild type FVB mouse.
Liver from a 2-week old AL-TAg transgenic FVB mouse showing increased density of basophilic hepatocytes.
A transient ductular formation of hepatocytes is seen in liver of this 2-week old AL-TAg mouse.
Bile duct proliferation in a 4-week old AL-TAg mouse. Some surrounding hepatocytes are dysplastic